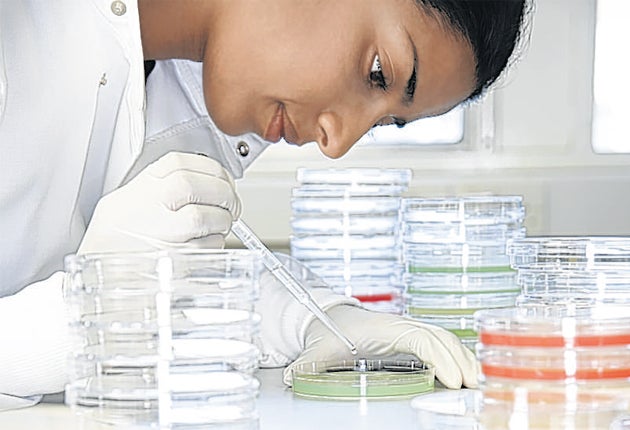
A few lucky students who missed their grades get on medicine courses

Medical Clearing: There's a narrow chance of survival, doctor...
It's a long shot, but don't dismiss medical Clearing just yet, writes Steve McCormack
Given that medicine is one of the most heavily subscribed subjects to study at university, with thousands of applications for courses with only a couple of hundred or so places, it’s almost unheard of for medical schools to use the Clearing system. But a small number of places every year do end up being filled this way. However, they usually appear for only an hour or so before they are snapped up.
Last year, no more than 100 places on medicine courses were allocated via Clearing, from a total of nearly 10,000 first-year places across 31 medical schools at UK universities. “You can get places through Clearing,” says Olivier Picard from ISC Medical, an organisation offering advice for people trying to land medical places, “but you have to have applied to the university in question in the first place to be considered. This is because different medical schools have very different styles of interviewing and selecting, so they’d not necessarily trust an applicant who hadn’t gone through their own system.”
While the number of places that go through Clearing is very small, almost all medical schools need to have a system to ensure they fill their full complement of places.
This is because they can never predict exactly how many of those students who’ve accepted places, conditional on A-level results, will actually achieve the required grades. Nor can medical schools predict how many students, who are holding an insurance offer with them, will end up claiming that place. So a Clearing-style operation, albeit on a relatively small scale, does go on at all medical schools. At Brighton and Sussex Medical School (BSMS), which has been training medical students since 2003, Mary Herns, the admissions tutor, knows she’ll have to fill a small proportion of the 140 first year places in this way. “We have a waiting list of people we have already interviewed, but who just didn’t quite score enough to be offered places,” she explains. “And, if we don’t have enough students who get the grades to be able to take up offered places, we’d go back to that waiting list, find out how they did in their A-levels and possibly offer them a place.”
At BSMS, as at all medical schools, there is scarcely any flexibility for the students who don’t get the required grades. However, in exceptional circumstances, claims Herns, some leniency is shown. “If someone narrowly fails to get the grades matching the exact terms of our offer we may, although it’s a big ‘may’, offer them a place if they did exceptionally well at interview,” she says.
At University College London Medical School, where 330 first years will start medicine degrees this autumn, history suggests that no more than half a dozen of them will have gained their places despite failing to meet their grades. Some years there are no places that need filling after the A-level |results come out.
“If there are vacancies, then we fill these by considering confirming the places of students who have only narrowly missed out on their offer,” says Dr Caroline Aspinwall, the school’s |admissions officer. “However no students who were unsuccessful in securing an offer at interview will be reconsidered at this stage.”
For those students set on a career in medicine who, because of disappointing exam results, are left without a place, there are still a couple of options to keep hopes alive.
The first is to resit A-levels next year, although not all medical schools accept applications from resit candidates. The second route to consider is to enter Clearing and look for a place on a three-year degree course in a relevant area, for example, biomedical science or pharmacy. This keeps open the possibility of, after graduation, applying for the four-year, graduate-entry version of a medicine degree-offered by numerous medical schools.
Join our commenting forum
Join thought-provoking conversations, follow other Independent readers and see their replies
Comments